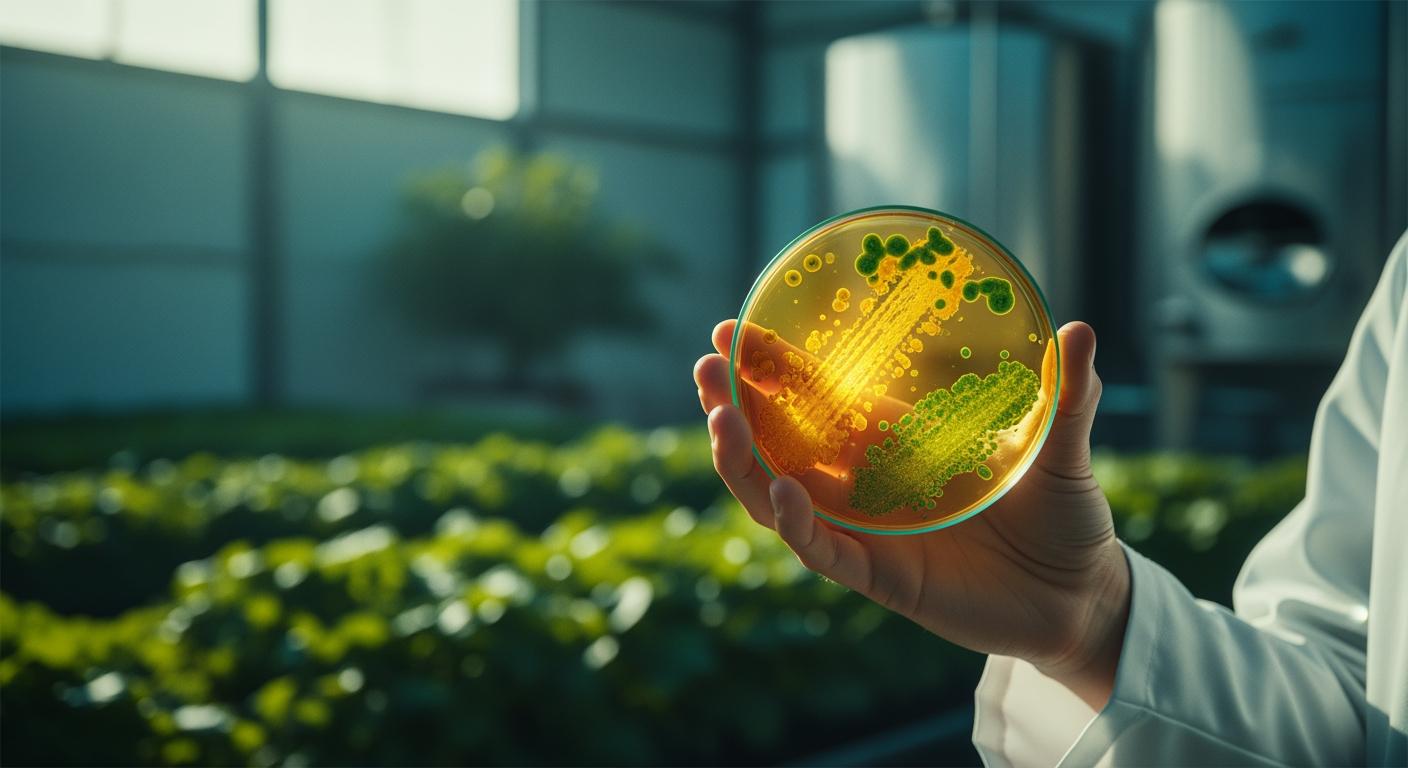

Tổng quan kỹ thuật lên men vi sinh trong nông nghiệp: Từ A-Z cho người mới
Bài viết Pillar cung cấp kiến thức nền tảng về quá trình lên men và men vi sinh trong nông nghiệp. Hướng dẫn chi tiết cách chọn lọc, nuôi cấy chủng men chuẩn xác để ứng dụng vào ủ phân, ủ thức ăn chăn nuôi mang lại hiệu quả kinh tế cao.
Key Takeaways: Tóm tắt kỹ thuật lên men vi sinh hiệu quả
Đất đai không tự nhiên mà màu mỡ; bản chất nó là một cỗ máy tiêu hóa sinh học khổng lồ. Và kỹ thuật lên men vi sinh chính là cách chúng ta đưa hàng tỷ "công nhân" siêu nhỏ vào cỗ máy đó. Nếu bạn từng xót xa nhìn đống rơm rạ, vỏ cà phê hay phân chuồng chất đống bốc mùi mà không biết làm gì, thì đây là lúc thay đổi tư duy. Quá trình này không phải là sự thối rữa ngẫu nhiên, mà là nghệ thuật làm chủ hệ vi sinh vật để biến phụ phẩm thành tài nguyên dinh dưỡng vô giá.
Nhiều người hỏi tôi tại sao kỹ thuật lên men quan trọng đến vậy? Hãy nhìn vào cơ chế vật lý của nó: thay vì để tự nhiên mất nửa năm ròng rã bẻ gãy các chất hữu cơ khó tiêu, việc đưa đúng chủng men vào giống như gắn động cơ turbo cho quá trình phân hủy. Các nhóm vi sinh vật phân giải cellulose xé toạc các liên kết hóa học cứng đầu, ép thời gian ủ phân từ 4-6 tháng xuống chỉ còn vỏn vẹn 1-2 tháng. Không chỉ vậy, các chủng mạnh như Bacillus hay Trichoderma còn tiết ra enzyme kháng sinh, tạo thành một lớp màng bảo vệ sinh học, ức chế triệt để nấm bệnh và tuyến trùng theo cơ chế đối kháng tự nhiên.
Làm nông mà không tính toán dòng tiền thì chỉ có nước bán đất. Lợi ích của kỹ thuật lên men vi sinh thể hiện rõ nhất qua những con số trên sổ nợ. Dưới đây là bức tranh tổng quan về hiệu quả khi bạn áp dụng đúng quy trình nuôi cấy men vi sinh chuẩn:
| Chỉ số mục tiêu | Hiệu quả đạt được | Cơ chế & Ghi chú kỹ thuật |
|---|---|---|
| Thời gian ủ hữu cơ | Giảm 60-70% thời gian | Rút ngắn từ 4-6 tháng xuống 1-2 tháng nhờ vi sinh phân giải cellulose. |
| Tiết kiệm chi phí | Giảm 40-50% tiền phân bón | Nhờ ứng dụng men vi sinh trong ủ phân tại chỗ; đồng thời giảm 20-30% lượng phân hóa học. |
| Xử lý mùi chăn nuôi | Tiêu diệt 90% vi khuẩn gây mùi | Hiệu quả cực nhanh chỉ trong vòng 24-48 giờ xử lý. |
| Chất lượng nông sản | Giảm hàm lượng Nitrate | Tăng thời gian bảo quản, cải thiện cấu trúc đất lâu dài. |
Để đạt được những con số "biết nói" trên, bí quyết cốt lõi nằm ở việc nhân sinh khối vi sinh vật tại chỗ. Lấy ví dụ về công nghệ EM (Effective Microorganisms) – một tổ hợp cộng sinh hoàn hảo giữa vi khuẩn quang hợp, vi khuẩn lactic và nấm men. Khi có hướng dẫn nuôi cấy men tại nhà đúng cách, bạn có thể tự tin ứng dụng chúng cho cả trồng trọt, thủy sản lẫn kỹ thuật lên men thức ăn chăn nuôi mà không phải phụ thuộc vào các chế phẩm đắt đỏ.
💡 Nông dân thực chiến lưu ý
Một trong những sai lầm khi nuôi cấy men vi sinh phổ biến nhất là pha sai tỷ lệ và lơ là môi trường ủ. Tỷ lệ pha loãng EM thứ cấp chuẩn phải dao động từ 1:20 đến 1:50. Nếu dùng để phun khử mùi chuồng trại thì pha đặc hơn, còn tưới cải tạo đất thì pha loãng ra. Đừng quên kiểm soát pH và nhiệt độ ủ – vi sinh vật cũng là sinh vật sống, nóng quá thì chết, lạnh quá thì ngủ đông.
Trong các phần tiếp theo của bài viết, chúng ta sẽ đi sâu vào việc so sánh các loại men vi sinh, phân tích cách chọn chủng men vi sinh phù hợp cho từng loại cây trồng, cũng như cách nhân giống chủng men vi sinh gốc và cách bảo quản chủng men vi sinh để dùng quanh năm. Dù bạn đang tìm hiểu kỹ thuật lên men vi sinh 2024, muốn biết mua chủng men vi sinh ở đâu tốt, cách tự làm men vi sinh nông sản hay đang xây dựng mô hình theo kỹ thuật lên men vi sinh chuẩn VietGAP, thì việc nắm vững nền tảng này là bắt buộc. Nhớ nhé: Chúng ta không ép cây lớn, chúng ta nuôi dưỡng đất, và đất sẽ tự biết cách nuôi cây.

Tại sao kỹ thuật lên men vi sinh là chìa khóa cho nông nghiệp bền vững?
Đổ hàng tấn phân bón NPK xuống một mảnh đất bạc màu giống như việc ép một người đang loét dạ dày phải ăn yến sào. Dinh dưỡng nằm phơi ra đó, nhưng rễ cây không thể "nhai" được, cuối cùng lại bị rửa trôi sau một trận mưa rào. Nhiều bà con hay hỏi tôi tại sao kỹ thuật lên men quan trọng đến vậy? Câu trả lời nằm ở cơ chế vật lý sinh học: Kỹ thuật lên men chính là việc chúng ta xây dựng một hệ tiêu hóa ngoại hàm khổng lồ cho khu vườn của mình.
Bản chất của kỹ thuật lên men là mượn sức mạnh của vi sinh vật để bẻ gãy các liên kết hóa học phức tạp. Những đống rơm rạ, vỏ cà phê hay phân chuồng vốn dĩ là những khối vật chất cứng đầu. Nhưng khi chúng ta biết cách tự làm men vi sinh nông sản và đưa đúng chủng vi sinh vật phân giải vào, chúng hoạt động như những cỗ máy nghiền siêu nhỏ. Thay vì chờ đợi tự nhiên mất 4 đến 6 tháng để hoai mục, ứng dụng men vi sinh trong ủ phân giúp rút ngắn thời gian xuống chỉ còn vỏn vẹn 1 đến 2 tháng. Toàn bộ chất hữu cơ khó tiêu được chuyển hóa thành dạng dinh dưỡng tinh chất mà rễ cây có thể hút ngay lập tức.
"Nông nghiệp bền vững không bắt đầu từ những tờ giấy chứng nhận hào nhoáng. Nó bắt đầu từ việc bạn biết cách nuôi dưỡng một nắm đất tơi xốp, thơm mùi mùn và tràn ngập sự sống ở dưới chân mình."
Nhưng giá trị của men vi sinh không chỉ dừng lại ở việc cung cấp thức ăn. Hãy nhìn nó dưới góc độ của một hệ thống phòng thủ sinh học. Trong tự nhiên, sự cạnh tranh sinh tồn là vô cùng tàn khốc. Khi bạn nắm vững quy trình nuôi cấy men vi sinh chuẩn, bạn đang thả một đội quân bảo vệ xuống đất. Các chủng chiến binh như Bacillus hay Trichoderma không tấn công nấm bệnh bằng hóa chất độc hại; chúng dùng cơ chế đối kháng sinh học. Chúng tiết ra các enzyme và kháng sinh tự nhiên để tiêu diệt nấm bệnh và ức chế tuyến trùng ngay từ trong giá thể, bảo vệ bộ rễ non nớt của cây trồng.
| Nhóm vi sinh vật cốt lõi | Cơ chế vận hành trong hệ thống | Lợi ích thực chiến trên đồng ruộng |
|---|---|---|
| Bacillus, Trichoderma | Tiết enzyme và kháng sinh tự nhiên (Cơ chế đối kháng) | Tiêu diệt nấm bệnh, làm sạch giá thể, tạo màng bảo vệ rễ cây. |
| Vi sinh vật phân giải Cellulose | Bẻ gãy cấu trúc hữu cơ phức tạp, khó tiêu | Rút ngắn thời gian ủ phân từ 6 tháng xuống 1-2 tháng, cung cấp dinh dưỡng nhanh. |
| Chế phẩm đa chủng (EM) | Cộng sinh (Vi khuẩn quang hợp, lactic, nấm men...) | Cải thiện cấu trúc đất lâu dài, ức chế vi khuẩn gây thối, khử mùi chuồng trại. |
Làm nông mà không tính toán dòng tiền thì mồ hôi đổ xuống cũng bằng không. Lợi ích của kỹ thuật lên men vi sinh thể hiện trực tiếp qua những con số trên sổ sách. Các nghiên cứu thực tế và kinh nghiệm từ những nhà vườn lão luyện cho thấy, việc duy trì hệ vi sinh vật khỏe mạnh giúp giảm từ 20% đến 30% lượng phân bón hóa học cần thiết. Đất tơi xốp hơn, giữ nước tốt hơn, và cây tự có sức đề kháng để lướt qua dịch bệnh.
Đây chính là nền tảng bắt buộc nếu bạn muốn xây dựng mô hình theo kỹ thuật lên men vi sinh chuẩn VietGAP hoặc hướng tới thị trường nông sản hữu cơ cao cấp. Không có vi sinh, bạn sẽ mãi mắc kẹt trong vòng lặp: Đất suy kiệt -> Đổ thêm phân hóa học -> Nấm bệnh bùng phát -> Đổ thêm thuốc trừ sâu -> Đất chết hoàn toàn.
💡 Góc nhìn từ người trong cuộc
Một trong những sai lầm khi nuôi cấy men vi sinh khiến bà con mất trắng mẻ ủ là coi vi sinh vật như một loại hóa chất vô tri. Chúng là sinh vật sống! Dù bạn đang tìm cách chọn chủng men vi sinh phù hợp cho cây ăn trái, hay áp dụng kỹ thuật lên men thức ăn chăn nuôi, nguyên tắc bất di bất dịch là phải kiểm soát pH và nhiệt độ ủ. Nóng quá thì men chết, lạnh quá thì men ngủ đông. Trước khi tìm hiểu xem mua chủng men vi sinh ở đâu tốt hay học cách nhân giống chủng men vi sinh gốc, hãy chắc chắn rằng bạn đã chuẩn bị một môi trường sống hoàn hảo cho chúng. Nắm vững cách bảo quản chủng men vi sinh cũng quan trọng không kém việc bạn gieo hạt giống xuống đất vậy.
Trong bối cảnh chi phí vật tư nông nghiệp ngày càng leo thang, việc cập nhật kỹ thuật lên men vi sinh 2024 không còn là một lựa chọn "làm cho vui" hay "làm theo phong trào" nữa. Dù bạn tự tìm hướng dẫn nuôi cấy men tại nhà hay mua chế phẩm sẵn, việc hiểu rõ bản chất của chủng men và nuôi cấy men chính là chìa khóa để giải phóng sức lao động, giảm thiểu rủi ro và trả lại sự sống đích thực cho mảnh đất của mình. Ở phần tiếp theo, chúng ta sẽ đi sâu vào việc so sánh các loại men vi sinh để xem đâu mới là "nhân công" phù hợp nhất cho mảnh vườn của bạn.

So sánh các loại men vi sinh và cách chọn chủng men phù hợp
Đứng trước một đống phân bò bốc mùi hay một hố ủ rác nhà bếp đang rỉ nước đen ngòm, nhiều người vội vàng đổ ụp bất kỳ chai men vi sinh nào mua được ngoài đại lý vật tư xuống. Đó là một lỗi hệ thống kinh điển. Việc chọn sai chủng men giống như bạn thuê một đội thợ mộc đi sửa đường ống nước: tốn tiền, mất việc, và đống rác thì vẫn hoàn rác. Để làm chủ kỹ thuật lên men, bạn phải hiểu "tính cách" và "năng lực" của từng nhóm thợ này.
Hiện nay, trên thị trường và trong các vườn thực chiến, chúng ta chia "công nhân vi sinh" thành ba lữ đoàn chính: men vi sinh gốc (EM1), men dạng bột và vi sinh bản địa (IMO). Sự khác biệt của chúng không nằm ở bao bì, mà nằm ở mật độ, trạng thái ngủ đông và khả năng thích nghi với môi trường vật lý.
| Tiêu chí | Men vi sinh gốc (EM1) | Men vi sinh dạng bột | Vi sinh bản địa (IMO) |
|---|---|---|---|
| Trạng thái | Dung dịch lỏng đậm đặc | Dạng hạt mịn hoặc bột | Tự nuôi cấy từ nguyên liệu địa phương |
| Thành phần | Đa chủng (Lactic, nấm men, quang hợp...) | Thường tập trung nhóm phân giải mạnh | Hệ vi sinh vật bản địa đa dạng |
| Độ ổn định | Cao, dễ kiểm soát chất lượng | Rất cao, thời gian bảo quản lâu | Phụ thuộc vào kỹ thuật nuôi cấy |
| Thích nghi | Trung bình | Trung bình | Rất cao với môi trường tại chỗ |
Men vi sinh gốc (EM1) thường chứa tổ hợp hàng chục loài vi sinh vật hữu ích sống cộng sinh dưới dạng lỏng. Lợi thế tuyệt đối của lữ đoàn này là tốc độ. Chúng cực kỳ xuất sắc trong việc xử lý mùi hôi và phân hủy chất thải lỏng nhanh chóng. Ngược lại, men vi sinh dạng bột lại là những chiến binh đang "ngủ đông" nhờ được trộn cùng các giá thể (chất mang). Trạng thái này giúp chúng có thời gian bảo quản cực lâu, rất phù hợp cho các quy trình phối trộn khô.
Đặc biệt nhất là chế phẩm vi sinh bản địa (IMO). Đây là những vi sinh vật "thổ địa" được phân lập và nhân nuôi từ chính mảnh vườn của bạn. Vì sinh ra và lớn lên ở đó, chúng có khả năng chống chịu tuyệt vời với khí hậu và thổ nhưỡng đặc trưng. Thực tế cho thấy, chỉ cần kết hợp IMO với việc che phủ đất bằng chất hữu cơ, rơm rạ hay cỏ khô tại chỗ, mật độ vi sinh vật bản địa sẽ tăng lên gấp nhiều lần. Chính hệ vi sinh này sẽ làm nhiệm vụ cày xới, giúp đất tơi xốp rõ rệt hơn hẳn so với việc lạm dụng phân bón hóa học.
Hướng dẫn "điều quân" theo mục đích sử dụng
Không có một loại men nào là "thần dược" trị bách bệnh. Việc cách chọn chủng men vi sinh phù hợp phải dựa trên đối tượng bạn muốn xử lý và môi trường cơ sở của nó.
- Khi ủ phân hữu cơ (Composting): Ưu tiên số một là các chủng men có khả năng bẻ gãy cấu trúc cứng đầu của Cellulose và Protein như Bacillus hoặc Trichoderma. Ở đây, men dạng bột là chân ái. Vì đống ủ thường duy trì độ ẩm ở mức 40-60%, việc rắc men bột giúp các bào tử phân tán đồng đều vào từng lớp nguyên liệu. Chúng sẽ làm nhiệm vụ chuyển hóa các chất dinh dưỡng khó tan thành dạng tinh chất dễ hấp thụ cho rễ cây. Đây là cốt lõi của việc ứng dụng men vi sinh trong ủ phân.
- Khi xử lý nước thải chăn nuôi hoặc ao hồ: Môi trường nước cần sự can thiệp ngay lập tức. Lúc này, các chế phẩm dạng lỏng như EM1 phát huy tối đa sức mạnh. Khả năng hòa tan tức thì giúp vi khuẩn quang hợp và vi khuẩn lactic bơi trực tiếp vào các chất hữu cơ lơ lửng, làm sạch nước và ức chế mầm bệnh sinh sôi.
- Khi làm đệm lót sinh học: Sự kết hợp giữa IMO và các chủng nấm men là bài toán kinh tế thông minh nhất. IMO giúp duy trì một hệ sinh thái vi sinh ổn định ngay trên nền chuồng, nuốt trọn các khí độc sinh ra từ phân và nước tiểu như NH3, H2S. Dùng vi sinh bản địa làm đệm lót không chỉ rẻ mà còn tạo ra môi trường thân thuộc nhất với hệ hô hấp của vật nuôi.
💡 Nông dân thực chiến lưu ý: Đánh giá chất lượng men bằng giác quan
Nhiều bà con hay băn khoăn mua chủng men vi sinh ở đâu tốt hay làm sao biết mẻ men tự ủ đã thành công. Thực ra, trước khi mang ra vườn, bạn có thể tự kiểm định chất lượng bằng mắt thường và khứu giác mà không cần máy móc phòng lab. Khi nuôi cấy men, dung dịch chuẩn phải có màu sắc đặc trưng (trong hoặc đục tùy loại) và BẮT BUỘC phải có mùi thơm chua nhẹ của quá trình lên men tự nhiên (giống mùi hèm rượu hoặc dưa muối). Nếu bạn mở nắp ra và ngửi thấy mùi hôi thối nồng nặc, mẻ đó đã nhiễm khuẩn tạp. Hãy đổ đi ngay để tránh rước mầm bệnh vào vườn!
Quy trình nuôi cấy và nhân giống chủng men vi sinh gốc tại nhà
Mua chế phẩm sinh học liên tục cho cả một trang trại rộng lớn giống như việc bạn đi mua nước đóng chai để tưới cây vậy — nó vắt kiệt dòng tiền của bạn. Thực tế, cách tự làm men vi sinh nông sản và tự nhân sinh khối từ chủng gốc là một trạm kiểm soát chi phí tuyệt vời, giúp bạn cắt giảm từ 80% đến 90% ngân sách so với việc mua can nhựa thương mại có sẵn.
Nhưng hãy nhớ, nuôi cấy men không phải là pha nước chanh. Bạn đang thực sự "chăn nuôi" hàng tỷ sinh vật sống bé nhỏ. Để cách nhân giống chủng men vi sinh gốc thành công, chúng ta cần thiết lập một hệ sinh thái thu nhỏ hoàn hảo cho chúng.
💡 Lỗi hệ thống chí mạng: Nước máy chứa Clo
Một trong những sai lầm khi nuôi cấy men vi sinh phổ biến nhất là xả thẳng nước máy vào thùng phuy. Clo trong nước máy là "khí độc" tiêu diệt vi sinh vật ngay lập tức. Nếu bắt buộc dùng nước máy, bạn phải bơm ra thùng, mở nắp và phơi ngoài không khí ít nhất 24 giờ để clo bay hơi hoàn toàn trước khi cho chủng men vào.
1. Chuẩn bị "khẩu phần ăn" và môi trường
Trong hướng dẫn nuôi cấy men tại nhà, môi trường dinh dưỡng là yếu tố sống còn. Vi sinh vật cần năng lượng để phân bào. Nguồn năng lượng rẻ và hiệu quả nhất chính là rỉ mật đường. Tùy thuộc vào cách chọn chủng men vi sinh phù hợp từ ban đầu, bạn sẽ phối trộn men mẹ (chủng gốc) với nước sạch đã khử clo, rỉ mật đường và các chất xúc tác sinh học như sữa chua, men rượu hoặc cám gạo. Những phụ phẩm này đóng vai trò như "bộ khởi động" giúp vi sinh vật tăng tốc độ sinh sản.
2. Thiết lập buồng ủ yếm khí
Sau khi khuấy đều, hỗn hợp phải được đưa vào thùng phuy nhựa có nắp đậy ron cao su thật kín. Quy trình nuôi cấy men vi sinh chuẩn bắt buộc phải diễn ra trong điều kiện ủ yếm khí (không có oxy) và tuyệt đối tránh ánh nắng mặt trời trực tiếp — tia UV sẽ phá hủy cấu trúc tế bào của men.
- Thời gian: Kéo dài từ 3 đến 5 ngày.
- Nhiệt độ ủ: Cần duy trì sự ổn định, để thùng ở nơi râm mát. Nhiệt độ quá cao sẽ làm "chín" men, quá thấp sẽ khiến chúng ngủ đông.
3. Khám sức khỏe "đàn vật nuôi" (Nghiệm thu)
Làm sao biết mẻ ủ của bạn đã thành công mà không cần mang tới phòng thí nghiệm? Khởi Nghiệp Nông Nghiệp thường khuyên bà con dùng chính giác quan của mình và một vài công cụ cơ bản để đánh giá kỹ thuật lên men:
| Tiêu chí | Dấu hiệu thành công (Men khỏe) | Dấu hiệu thất bại (Nhiễm khuẩn) |
|---|---|---|
| Kiểm soát pH | Độ pH giảm xuống dưới 4.0 (môi trường axit ức chế vi khuẩn có hại). | pH cao trên 5.0, không có tính axit bảo vệ. |
| Khứu giác & Thị giác | Mùi thơm chua ngọt nhẹ đặc trưng (như mùi hèm rượu, trái cây lên men), dung dịch chuyển màu chuẩn. | Mùi hôi thối, chua loét khó chịu, nổi váng mốc đen/xanh. |
| Test hoạt lực | Múc một ít men cho vào ly nước đường, thấy hiện tượng sủi bọt khí mạnh mẽ (vi sinh đang thở và ăn). | Mặt nước im lìm, không có phản ứng sinh hóa. |
4. Tái đàn và đưa xuống đất
Khi đã có mẻ men thứ cấp đạt chuẩn, cách bảo quản chủng men vi sinh tốt nhất là trích lại một phần dung dịch làm "men cái" để tiếp tục nhân giống cho mẻ sau, tạo thành một vòng lặp liên tục không bao giờ cạn kiệt.
"Đừng chỉ tưới men xuống đất trống. Hãy kết hợp tưới men lên lớp rơm rạ, cỏ khô hoặc phân hữu cơ đang che phủ bề mặt. Vi sinh vật sẽ phân hủy rơm rạ tại chỗ, chuyển hóa dinh dưỡng khó tan thành dạng dễ hấp thụ. Chỉ sau một thời gian ngắn, bạn sẽ thấy đất tơi xốp hơn rõ rệt so với việc cày xới và đổ phân hóa học."
— Sổ tay Khởi Nghiệp Nông Nghiệp
Bằng cách làm chủ hệ thống vi sinh này, bạn không chỉ đang xử lý chất thải hay ủ thức ăn chăn nuôi, mà đang thực sự xây dựng một nhà máy sản xuất phân bón sống ngay dưới chân mình.

Ứng dụng kỹ thuật lên men trong ủ phân và sản xuất thức ăn chăn nuôi
Trong nông nghiệp, lợi nhuận không nằm ở việc bạn đổ bao nhiêu tiền vào vật tư, mà nằm ở việc vật nuôi và cây trồng thực sự hấp thụ được bao nhiêu. Phần cám ngô đi thẳng qua đường ruột lợn rồi thải ra ngoài, hay đống phân bò tươi ủ sai cách làm thối rễ sầu riêng — dưới góc nhìn hệ thống, đó là sự rò rỉ tài nguyên trầm trọng. Ứng dụng men vi sinh trong ủ phân và chế biến thức ăn chính là cách chúng ta "bịt" lỗ rò rỉ này lại, biến phế phụ phẩm thành dòng tiền thực tế.
1. Kỹ thuật lên men thức ăn chăn nuôi: Cỗ máy "làm chín sinh học"
Đừng bắt dạ dày con lợn, con bò của bạn làm việc quá sức. Việc cho ăn thô (cỏ voi nguyên cây, cám sống) tốn rất nhiều năng lượng cơ thể để tiêu hóa. Kỹ thuật lên men thức ăn chăn nuôi bản chất là quá trình "làm chín sinh học" mà không cần củi lửa. Chúng ta mượn sức của các chủng vi sinh (chủ yếu là Lactobacillus) để cắt đứt các phân tử tinh bột phức tạp thành đường đơn và axit amin ngay từ bên ngoài cơ thể vật nuôi.
💡 Nguyên tắc sống còn: Ép kiệt không khí
Ủ chua là một quá trình lên men yếm khí (kỵ khí) tuyệt đối. Lỗi sai kinh điển của bà con là nén không chặt. Bạn bắt buộc phải băm nhỏ nguyên liệu để tăng diện tích tiếp xúc cho men, sau đó nén thật chặt trong bao hoặc hố ủ để đuổi sạch oxy ra ngoài. Có oxy là nấm mốc phát triển, hỏng cả mẻ ủ.
Để kích hoạt cỗ máy sinh học này, kinh nghiệm thực chiến của chúng tôi là bổ sung 3-5% rỉ mật đường (làm thức ăn khởi động cho vi khuẩn Lactic) và 0,5% muối để tăng độ ngon miệng. Kết quả mang lại vô cùng rõ rệt:
- Tăng trưởng vượt trội: Dữ liệu thực tế cho thấy đàn dê sử dụng thức ăn ủ chua có tốc độ tăng trưởng nhanh hơn 15-20% so với việc nhai cỏ tươi trực tiếp.
- Cải thiện môi trường: Thức ăn được tiêu hóa triệt để giúp giảm từ 50-70% mùi hôi thối từ phân và nước tiểu.
- Lưu trữ chiến lược: Một mẻ ủ chuẩn chỉnh có thể bảo quản an toàn từ 3 đến 6 tháng (thậm chí lên tới 9 tháng) mà không hao hụt dinh dưỡng, giúp bà con chủ động nguồn thức ăn qua mùa đông.
2. Ủ phân hữu cơ vi sinh: Trả lại sự sống cho đất
Đưa phân tươi trực tiếp xuống vườn chẳng khác nào ép cây uống thuốc độc. Quá trình phân hủy tự nhiên sinh ra nhiệt và khí độc sẽ làm cháy rễ non. Bằng cách đưa các chủng vi sinh mạnh như Bacillus và nấm đối kháng Trichoderma vào đống ủ, chúng ta đang ép hệ thống phân hủy tự nhiên chạy ở tốc độ cao nhất.
- Rút ngắn thời gian: Thay vì chờ đợi 4-6 tháng ròng rã theo cách truyền thống, kỹ thuật lên men chuẩn giúp đống phân hoai mục hoàn toàn chỉ trong 30-45 ngày.
- Tỷ lệ vàng: Phối trộn nguyên liệu sao cho tỷ lệ C/N (Carbon/Nitơ) đạt khoảng 30/1, độ ẩm duy trì ở mức 50-60%. Nắm chặt một nắm phân ủ, thấy rỉ nước ở kẽ tay nhưng không nhỏ giọt là đạt chuẩn.
- Lò thiêu mầm bệnh: Khi vi sinh vật hoạt động mạnh, nhiệt độ đống ủ sẽ tăng vọt. Chỉ cần duy trì mức nhiệt trên 55 độ C trong 3 ngày liên tiếp, toàn bộ hạt cỏ dại và các loại nấm gây bệnh xì mủ, thối rễ tồn dư sẽ bị tiêu diệt hoàn toàn.
Tỷ lệ phối trộn thực tế rất tiết kiệm: chỉ cần 1-2kg men vi sinh gốc cho 1 tấn phân chuồng. Việc kết hợp đúng chủng vi sinh phân giải và đối kháng không chỉ tạo ra nguồn phân bón sạch mà còn là lớp khiên bảo vệ hệ sinh thái đất bền vững.
| Thông số hệ thống | Lên men thức ăn chăn nuôi | Ủ phân hữu cơ hoai mục |
|---|---|---|
| Mục tiêu cốt lõi | Làm chín sinh học, tăng hấp thụ (15-20%) | Phân hủy nhanh (30-45 ngày), diệt mầm bệnh |
| Chủng vi sinh chủ lực | Lactobacillus, nấm men | Bacillus, Trichoderma |
| Điều kiện môi trường | Kỵ khí tuyệt đối (băm nhỏ, nén thật chặt) | Độ ẩm 50-60%, nhiệt độ >55°C |
"Trong nông nghiệp, không có rác thải, chỉ có nguồn tài nguyên đang bị đặt sai chỗ. Và kỹ thuật lên men vi sinh chính là chiếc chìa khóa để đưa chúng về đúng vị trí sinh lời."
— Khởi Nghiệp Nông Nghiệp

Những sai lầm thường gặp và cách bảo quản chủng men vi sinh
Mùi hôi thối bốc lên từ hố ủ không phải là dấu hiệu cho thấy bạn kém cỏi hay lười biếng. Dưới góc nhìn của Khởi Nghiệp Nông Nghiệp, đó đơn giản là tiếng thét của một hệ sinh thái đang sụp đổ. Trong kỹ thuật lên men, vi sinh vật là những công nhân mẫn cán nhất, nhưng chúng vận hành theo các định luật vật lý và hóa học khắt khe. Chỉ một sai lệch nhỏ về hạ tầng môi trường, bạn sẽ vô tình biến "nhà máy sản xuất dinh dưỡng" thành một mồ chôn tập thể.
Lỗi hệ thống: Khi chúng ta vô tình "bóp nghẹt" vi sinh vật
Những sai lầm khi nuôi cấy men vi sinh thường bắt nguồn từ việc chúng ta không hiểu cơ chế sinh tồn của chúng. Lỗi kỹ thuật kinh điển nhất tại các nông hộ là mất kiểm soát độ ẩm và nguồn nước.
- Cơn lũ ngạt thở (Độ ẩm > 70%): Khi bạn tưới quá nhiều nước vào đống ủ phân, các khe hở chứa oxy bị lấp đầy. Nồng độ oxy giảm mạnh khiến hệ vi sinh vật hiếu khí bị tiêu diệt. Lúc này, các vi khuẩn yếm khí sinh khí độc chiếm ưu thế, giải phóng khí \(H_2S\) tạo ra mùi trứng thối đặc trưng.
- Thuốc độc từ vòi nước (Clo > 0.5mg/l): Nước máy tiện lợi, nhưng lượng Clo dư thừa vượt mức 0,5mg/l là chất kịch độc đối với bào tử nấm và vi khuẩn có lợi. Việc pha loãng chế phẩm bằng nước máy trực tiếp sẽ làm sụt giảm mật độ vi sinh vật nghiêm trọng. Hãy bơm nước ra phi, phơi nắng 1-2 ngày để Clo bay hơi hết trước khi dùng.
- Sự pha trộn chết chóc: Nguyên tắc cốt lõi là tuyệt đối không trộn lẫn men vi sinh với bất kỳ loại hóa chất diệt khuẩn, vôi bột sống hay thuốc bảo vệ thực vật nào cùng một lúc. Đó là hành động tự triệt tiêu lực lượng lao động của chính mình.
Quy chuẩn lưu trữ: Cách bảo quản chủng men vi sinh tại nông hộ
Mua được men tốt đã khó, giữ cho chúng sống sót chờ đến ngày ra vườn lại càng khó hơn. Tế bào vi sinh vật cực kỳ nhạy cảm với bức xạ. Tia cực tím (UV) trong ánh nắng mặt trời giống như một quả bom hạt nhân, có khả năng xuyên thủng màng tế bào và tiêu diệt chúng chỉ trong thời gian ngắn tiếp xúc. Do đó, cách bảo quản chủng men vi sinh cốt lõi là: Khô ráo, thoáng mát và bóng tối tuyệt đối.
Dưới đây là thời hạn sử dụng thực tế dựa trên dạng vật lý của chế phẩm mà bạn cần nắm rõ:
| Dạng chế phẩm | Thời hạn sử dụng khuyến cáo | Đặc điểm lưu ý tại nông hộ |
|---|---|---|
| Dạng lỏng | 6 - 12 tháng | Dễ bị sốc nhiệt, sinh khí làm phình can/chai. Cần nới lỏng nắp định kỳ nếu thấy chai căng cứng để xả khí. |
| Dạng bột/viên nén | 1 - 2 năm | Độ ổn định cao, bào tử ngủ đông tốt. Phù hợp để dự trữ lâu dài trong kho vật tư, nhưng phải bọc kín tránh hút ẩm. |
Làm chủ nhiệt độ và "bắt bệnh" qua cảm quan
Nhiệt độ là chiếc nhiệt kế đo lường sức khỏe của mẻ ủ. Mức nhiệt lý tưởng để vi sinh vật sinh sôi dao động từ 25-35 độ C. Tuy nhiên, như đã đề cập, đống ủ phân hữu cơ có thể bốc khói và đạt ngưỡng 60-70 độ C. Dù mức nhiệt này tốt cho việc diệt cỏ dại, nhưng nếu để kéo dài quá lâu, chính các vi sinh vật có lợi cũng sẽ bị "luộc chín". Giải pháp cơ học lúc này là phải định kỳ đảo trộn đống ủ để tản nhiệt và cấp lại oxy.
💡 Bộ đệm sinh học
Trong quá trình ủ, môi trường có thể bị axit hóa (pH giảm sâu) làm ức chế vi sinh. Việc bổ sung thêm lân nung chảy ngay từ đầu đóng vai trò như một bộ đệm hoàn hảo, vừa ổn định pH, vừa tăng cường khoáng chất cho mẻ phân sau này.
Cuối cùng, để biết mẻ ủ thành công hay thất bại mà không cần phòng thí nghiệm, hãy dùng thị giác của một người làm vườn thực thụ: Giữ được màu tự nhiên của nguyên liệu, có lớp men trắng mỏng bám đều, và tuyệt đối không xuất hiện các vệt mốc đen, mốc vàng rực (dấu hiệu của nấm độc Aspergillus).
Ngày mai, khi bước ra xưởng ủ, hãy nhớ rằng bạn không chỉ đang trộn rác hay băm cỏ. Bạn đang kiến tạo và quản lý một hệ sinh thái thu nhỏ. Hiểu ranh giới sinh tử của chúng, bạn sẽ nắm trong tay chìa khóa của nền nông nghiệp chi phí thấp.

FAQ: Giải đáp thắc mắc về kỹ thuật lên men vi sinh nông nghiệp
Ra đến thực địa, lý thuyết trên giấy thường va chạm nảy lửa với thực tế lấm bùn. Đứng trước một mẻ ủ bốc mùi hay một thùng men sủi bọt bất thường, bạn không cần một cuốn bách khoa toàn thư, bạn cần một công cụ chẩn đoán lỗi hệ thống. Dưới đây là những câu hỏi xương máu mà Khởi Nghiệp Nông Nghiệp thường xuyên nhận được từ các nhà vườn, được giải mã dưới lăng kính của cơ chế sinh học.
1. Mua chủng men vi sinh ở đâu tốt và tiêu chí nào để "khám sức khỏe" mẻ men?
Nhiều người lầm tưởng mua men là mua một loại hóa chất. Không, bạn đang thuê một đội quân vi sinh vật đánh thuê. Sự thành bại của kỹ thuật lên men phụ thuộc 70% vào sức chiến đấu của đội quân này. Khi tìm kiếm mua chủng men vi sinh ở đâu tốt, đừng chỉ nhìn vào nhãn mác bắt mắt. Hãy nhìn vào các chỉ số sinh tồn.
- Mật độ tế bào (CFU): Một sản phẩm chuẩn phải ghi rõ mật độ đạt từ \(10^8\) đến \(10^9\) CFU/ml (hoặc gram). Dưới con số này, đội quân của bạn quá mỏng để áp đảo các vi khuẩn gây hại trong môi trường tự nhiên.
- Bao bì và quy cách: Vi sinh vật rất nhạy cảm. Nếu bao bì phình to bất thường (do sinh khí quá mức) hoặc bị phơi dưới nắng gắt tại đại lý, hoạt tính sinh học bên trong có thể đã bị tiêu diệt. Cách chọn chủng men vi sinh phù hợp là ưu tiên các đơn vị có chứng nhận kiểm định rõ ràng và hướng dẫn bảo quản khắt khe.
2. Làm sao để "bắt mạch" hố ủ? Dấu hiệu nào cho thấy lên men đạt yêu cầu?
Một trong những sai lầm khi nuôi cấy men vi sinh là ủ xong rồi nhắm mắt bón đại xuống đất. Việc kiểm soát chất lượng sau ủ là chốt chặn cuối cùng để bảo vệ cây trồng. Một hệ sinh thái lên men thành công sẽ phát ra những tín hiệu vật lý rất rõ ràng:
- Khứu giác (Mùi hương): Mẻ ủ chuẩn sẽ tỏa ra mùi chua nhẹ đặc trưng của axit hữu cơ hoặc mùi thơm nồng của rượu (ethanol). Nếu bạn ngửi thấy mùi hôi thối thốc lên hoặc mùi khai nồng nặc của amoniac, hệ thống đã sụp đổ. Vi khuẩn thối rữa đã chiếm quyền kiểm soát.
- Thị giác (Màu sắc): Nguyên liệu sẽ chuyển sang màu nâu sáng hoặc giữ màu đặc trưng của chủng men. Tuyệt đối không được có sự xuất hiện của các đốm nấm mốc đen hoặc xanh lục lạ thường.
- Chỉ số pH: Đây là thước đo định lượng sinh tử. Kiểm soát pH tốt là khi chỉ số này tụt xuống dưới mức 4.5. Tại ngưỡng axit này, vi khuẩn lactic đã thiết lập thành công vùng an toàn, khóa chặt và ức chế hoàn toàn các vi sinh vật gây thối.
3. Có nên tự ý phối trộn nhiều loại men (đa chủng) với nhau để tăng tác dụng?
Tư duy "càng nhiều càng tốt" là một cái bẫy. Việc đổ lộn xộn các chai men khác nhau vào cùng một thùng ủ không tạo ra sức mạnh cộng hưởng, mà tạo ra một cuộc nội chiến sinh học. Các chủng vi sinh sẽ cạnh tranh khốc liệt nguồn dinh dưỡng, hoặc tiết ra chất đối kháng tiêu diệt lẫn nhau.
"Đừng tự ý ghép nhốt những kẻ săn mồi vào cùng một chuồng nếu bạn không hiểu rõ tập tính của chúng."
Thay vì tự làm kỹ sư sinh học rủi ro cao, hãy sử dụng các chế phẩm vi sinh tổng hợp đã được nghiên cứu bài bản như EM (Effective Microorganisms). Cấu tạo của chế phẩm EM là một xã hội cộng sinh hoàn hảo, nơi vi khuẩn quang hợp, vi khuẩn lactic và nấm men Saccharomyces cùng chung sống, hỗ trợ nhau phân giải hữu cơ và ức chế mầm bệnh. Ngoài ra, các chủng như Bacillus hay Trichoderma khi được phối trộn đúng chuẩn có khả năng tiết ra enzyme kháng sinh, trực tiếp tiêu diệt nấm bệnh và tuyến trùng trong giá thể.
4. Tại sao kỹ thuật lên men quan trọng? Con số thực tế mang lại là gì?
Nếu bạn vẫn đang tự hỏi tại sao kỹ thuật lên men quan trọng, hãy nhìn vào dòng tiền và thời gian. Lợi ích của kỹ thuật lên men vi sinh không nằm ở những lời hứa hẹn viển vông, mà nằm ở hiệu suất chuyển hóa năng lượng:
- Hack thời gian: Vi sinh vật phân giải cellulose hoạt động như những cỗ máy nghiền siêu tốc, giúp rút ngắn thời gian ứng dụng men vi sinh trong ủ phân hữu cơ từ 4-6 tháng ròng rã xuống chỉ còn 1-2 tháng.
- Mở khóa dinh dưỡng: Chúng chuyển hóa các khối dinh dưỡng khó tan trong đất thành dạng ion dễ hấp thụ, cải thiện cấu trúc đất và tăng độ phì nhiêu lâu dài.
- Cắt giảm chi phí: Theo các số liệu thực chứng, việc duy trì một hệ vi sinh khỏe mạnh giúp nhà vườn giảm từ 20-30% lượng phân bón hóa học và thuốc bảo vệ thực vật cần thiết.
💡 Mẹo thực chiến từ Khởi Nghiệp Nông Nghiệp
Dù bạn áp dụng hướng dẫn nuôi cấy men tại nhà hay kỹ thuật lên men thức ăn chăn nuôi quy mô lớn, hãy nhớ nguyên tắc "Nhiệt độ và Độ ẩm". Độ ẩm lý tưởng luôn phải duy trì ở mức 45-60%. Vắt một nắm nguyên liệu ủ, nếu nước rỉ ra kẽ tay là quá ướt (thiếu oxy, gây thối), nếu tơi lả tả là quá khô (vi sinh vật ngừng hoạt động). Nhiệt độ ủ cũng cần được theo dõi sát sao để không luộc chín chính đội quân vi sinh của bạn.